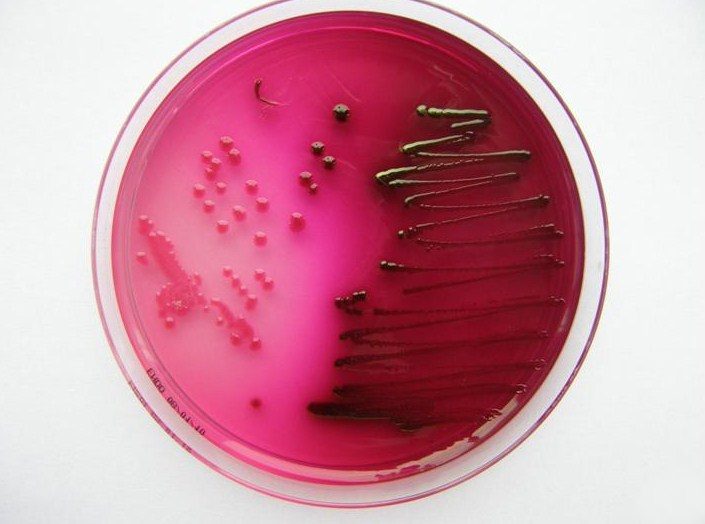

Labordiagnostik
Labordiagnostik
weiterlesen
Meine Mitarbeiterinnen und ich führen eine Reihe von Laboruntersuchungen in unserer Praxis durch. Neben der orientierenden Untersuchung des Urins mittels automatisch ausgelesenem Harnstreifentest erfolgt eine Untersuchung des Urinsedimentes mit dem Mikroskop. Hierbei wird Ihr Urin auf Veränderungen Ihres Stoffwechsels (u.a. Glucoseausscheidung), das Vorhandensein von Blut und Anzeichen einer Infektion untersucht. Eine weiterführende Untersuchung des Urins erfolgt mittels einer Bakterienkultur in unserem Labor. Hierbei wird diagnostiziert um welches Bakterium oder welche Pilze es sich bei einer Infektion handelt und es wird eine Resistenzbestimmung durchgeführt. Hierbei wird festgestellt, welche antibiotische Therapie am besten geeignet ist, um eine Infektionserkrankung des Urogenitaltraktes zu therapieren. Die Qualität unserer Diagnostik überprüfen wir 1-2 x jährlich in Ringversuchen mit anderen Laboren.
Neben der umfassenden Urindiagnostik wird in dem Labor unserer Praxis Hormondiagnostik im Rahmen individueller Gesundheitsleistungen mit modernen Analysegeräten durchgeführt.
Nehmen Sie Kontakt auf!
Kompetenzen
Wir sind Spezialisten auf unserem Gebiet.
In folgenden Bereichen können wir Ihnen helfen und Auskunft geben:
